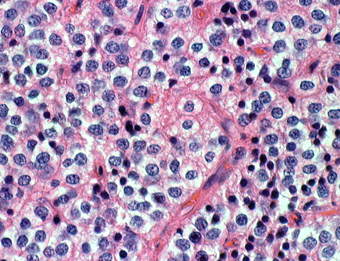

中枢性神経細胞腫 central neurocytoma セントラルニューロサイトーマ
- 思春期と若い成人の頭の中心部の側脳室の中にできます
- ゆっくり大きくなって水頭症にならないと症状がでないので大きなものが多いです
- 頭痛と視力障害が症状です
- 良性ですのでWHOのグレード2です(ほとんど1のようなものです)
- まれな腫瘍で全脳腫瘍の0.5%以下とされてきました
- もで,実はまれではなくて,最近はMRIで偶然発見されるものも多いです
- 患者さんが高齢になると腫瘍も自然に小さくなるという自然退縮がみられる良性腫瘍です
- 年齢が高くて症状がない場合には治療をしません
- CTでは石灰化 (50%) がみれますし,MRIではのう胞が見られて(80%) 造影剤で白く増強(全例)されます
- ほとんどが脳室の前の方でモンロー孔というところの近くにできるのが特徴です
- 頭の中心部にあって透明中隔というところあたりから発生して脳室の壁にベタベタくっついています
- ものすごくまれに脳室の外の脳の中にできます extraventricular neurocytoma
- 手術は開頭術で経脳梁到達法 (transcallosal approach) あるいは経皮質到達法 (transcortical approach)というのを選びます
- 大きな腫瘍で脳室の中にありけっこう出血しますから全摘出は簡単ではありません
- 全部取ると治りますが,無理な全摘出は脳弓損傷(記憶,認知障害)などの障害を残します
- とくに腫瘍と脳室の壁の間に脳室上衣下静脈というのがあり,この静脈の損傷は脳の深いところに脳梗塞を生じます
- 脳の深部の静脈性梗塞は,意識障害,認知障害,半身麻痺,言語の障害などの重い後遺症を残すことがあります
- ですから手術はとっても難しいということです
- 手術で取り残しても大きくならないこともあるのでしばらくは観察します
- 手術で残った腫瘍に放射線治療は有効です
- 浸潤性の腫瘍ではないので放射線治療は三次元原体照射,定位放射線照射,強度変調放射線治療 (IMRT)を使います
- それ以外の放射線治療では正常な脳に放射線が入ってしまいます
- 大きな腫瘍に放射線治療をしてはいけません,遅発性の放射線障害で認知症になるからです
- 再発(再燃)した腫瘍や放射線治療後にさらに大きくなってしまった腫瘍には再手術が有効です
- ICEとかPCVとかの化学療法も有効なのですが,化学療法だけでは治らないと考えた方がいいです
- かつては脳室内の乏突起膠腫と病理診断されていました
- 病理像で退形成性 anaplasiaがあっても悪性とは限りません
- 最初に良性のものが悪性化したという報告はありません
- 病理染色でMIB-1というのが2%以上染まるものは早く大きくなるあるいは再発するので注意しなければなりません
典型的な例
20代の男性の神経細胞腫です。側脳室の中のとても大きな腫瘍です。上段はガドリニウムという造影剤を入れた時のMRIです。下段の中央はCTですが,石灰化が見られます。脳外科の先生には,この脳室内腫瘍は一見transcallosal approach(経脳梁到達法)という手術で取れるように見えるかもしれませんが,そうではなくて,脳室の壁とくに上壁と側壁にくっついているのでなかなか取れません。この患者さんの場合は右の頭頂葉というところからtranscortical approach(経皮質到達法)で全摘出しました。後遺症もなく再発もなく術後10年が過ぎています。全部とれれば治ってしまう腫瘍です。
偶然発見された小さなもの
無症状で見つかった小さいcentral neurocytomaのCT像です
下は,病理像です。均一な丸い核を持った細胞が密に配列していますがPNETのような未分化腫瘍ではなくて良性の腫瘍です。ちょっと見には乏突起膠腫にとても似ているので,1980年代までは脳室内乏突起膠腫 (intraventricular oligodendroglioma) と呼ばれていました。シナプトフィジンやNSEという特殊染色で染まるので確定病理診断がつきます。
非定型 中枢性神経細胞腫 atypical central neurocytoma
- 真の悪性腫瘍ではなく,定義ははっきりしません
- necrosis, mitosis (>3/10 hpf), nuclear atypia, MIb-1 (>2%), endothelial proliferationがみられるものです
- このような病理像を呈するとatypical central neurocytomaと診断されます
- 完全摘出できなかった手術後に放射線治療を加えるべきかどうかは判然としません
- 幸いなことにこのタイプでも生命予後は悪くはありません
- もし広範囲の放射線治療をしなければならない時には,再手術を考慮したほうがいいでしょう
無症状の若い女性に偶然発見された例
central neurocytomaは腫瘍実質部分が多いものです。しかし,この例のように腫瘍の大部分をのう胞が占める症例もあります。
anterior transcallosal apprroachで亜全摘出しました。20代の女性でしたが,その後,子どもも生まれて元気です。
腫瘍の位置から,透明中核が発生母地であることが推測されます。central neurocytomaは,惻脳室壁にべとべとくっつくので,脳質上衣からの剥離は簡単ではありません。鑑別しなければならないのが,成人の毛様細胞性星細胞腫ですが,この症例では決定的な鑑別点はないでしょう。のう胞性の毛様細胞性星細胞腫と同様に,腫瘍の増殖力は低く無理して全摘出するものではありません。
70歳女性に偶然発見された例
- 偶然発見されたものには増大しないものがあります
- 無治療で経過観察してよいものがあります
incidental tumor 偶発腫といいます。病理診断はないのですが,まず間違いなくcentral neurocytomaで,数年間の観察で全く増大しませんでした。高齢の患者さんでは無症候で発見し,経過を見ていくと嚢胞変性を来たし,自然退縮していくものも見られす。この例でも,左のモンロー孔は閉塞していて,左側脳室は水頭症となっていますが,無症候です。おそらくこの腫瘍は今後も症候性となることはありません。センロラルニューロサイトーマは,神経鞘腫と同様に加齢によって変性し退縮する自然歴を有している腫瘍です。
文献
Leenstra JL, et al.: Central neurocytoma: Management recommendation based on a 35-year experience. Int J Radiat Oncol Biol Phys 67: 1145-1154, 2007
Mayoからの報告で最大のシリーズです。
畑中佳奈子の症例と病理教室
無症状で偶然発見された38歳女性の症例
central neurocytomaが透明中隔 septum pellucidum から発生していることがよくわかる症例です。症状はありませんでしたが,この腫瘍がこのままのサイズで留まることはあり得ないので手術摘出を勧めました。これ以上大きくなると手術にしても放射線治療にしてもリスクが大きくなりすぎます。脳弓にくっつくので脳弓損傷を避けるのが手術のポイントです。脳室壁にくっつくのですが剥がしていけば取れますが,大きな上衣下静脈 large subependymal vein の損傷には注意を払います。

手術後の画像です。脳神経外科の先生は手術根 surgical track に注目して下さい,左頭頂葉皮質切開 transcortical approachで手術を行っています。このルートでは全く手術後の神経脱落症状が出ませんでした。central neurocytomaの手術方法は,上記に加えて前頭葉皮質切開でまっすぐ前角に入る方法と経脳梁法 transcallosal approachがあります。経脳梁法は限られた小さめの腫瘍にしか応用できません。anterior callosal approach以外ではdisconnection syndromeが出るからです。central neurocytomaは脳室の壁にベトベトくっつくし,anterior callosal approachでは脳室壁の観察はかなり限られるからです。大きなものでは必ず経皮質法を選択して下さい。
病理所見
石灰化(画面右側の紫色の部分)とともに、均一な大きさの円形の核を有する腫瘍細胞が敷石状に配列している。
核周囲は明るく抜けている。腫瘍細胞間には細い血管が介在し、腫瘍細胞を区画している。
腫瘍細胞間には好酸性(ピンク色)の細線維性基質が認められる。
免疫染色(Olig2)。HE染色で核周囲が明るく抜ける形態からoligodendrogliomaが鑑別となるが、Olig2は陰性で、oligodendrogliomaは否定される。
免疫染色(Synaotphysin:神経内分泌marker)。腫瘍細胞間の細線維性基質に陽性を示す。